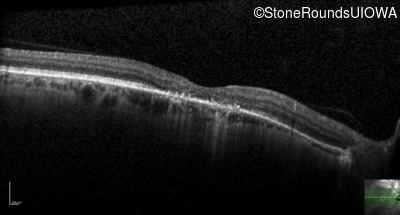
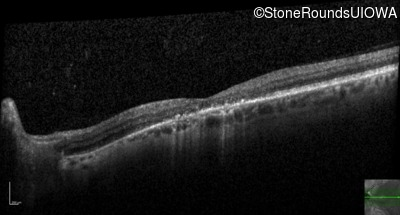
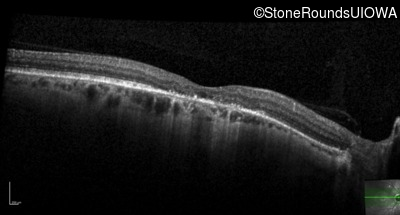
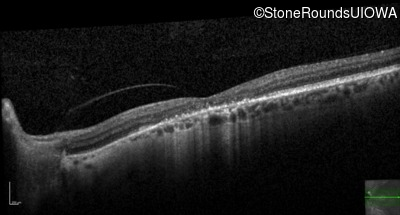
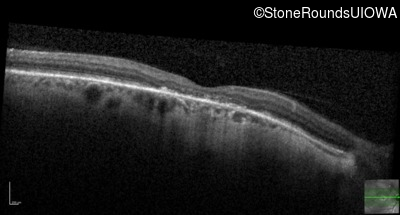
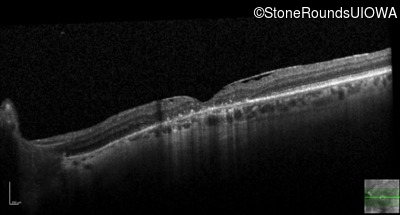
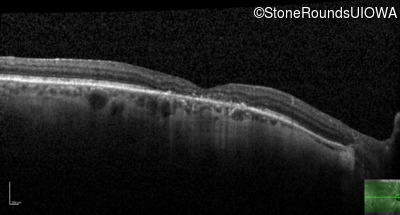
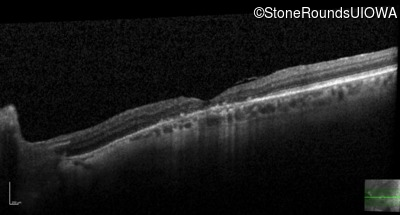
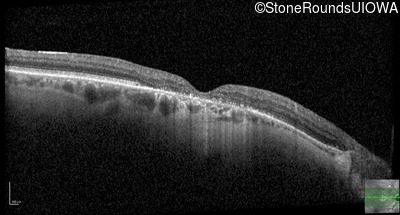
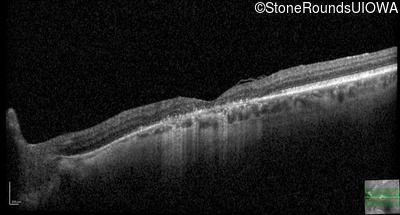
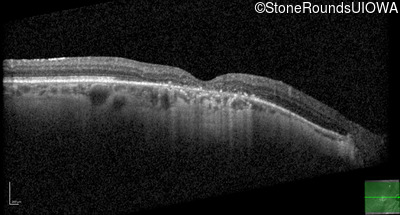
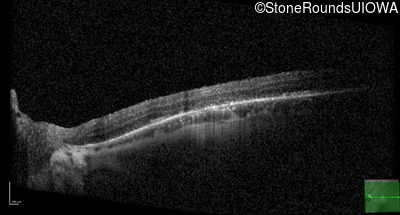

Case
SR217
Student Mode
XL Cone and Cone Rod Dystrophy (IA1bi)
Male
Male
Hidden
SR217
Student Mode
XL Cone and Cone Rod Dystrophy (IA1bi)
Male
Male
History
This 52 year old man had normal vision until his mid 30's when he began to have trouble distinguishing colors. the issuing 10 years he had a gradual loss of visual acuity accompanied by increasing photophobia.
| Age at visit: 55 years |
| Age at visit: 58 years |
| Age at visit: 61 years |
| Age at visit: 64 years |
Diagnosis & molecular findings
| Disease | Gene | Allele 1 variant(s) | Allele 2 variant(s) | Inheritance mode |
|---|---|---|---|---|
| XL Cone and Cone Rod Dystrophy | RPGR | Gly1093 del2gGA | XL |
Disease:
Gene:
Allele 1:
Gly1093 del2gGA
Allele 2:
Inheritance:
XL